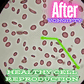
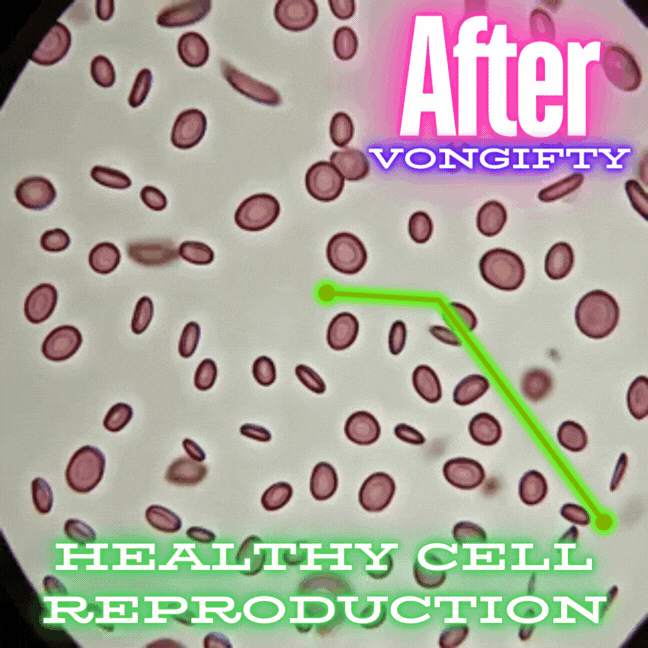

WHAT DO OUR GIFTY-Girls THINK?
Couldn't load pickup availability
PureFirst Milk™ Colostrum Powder - Women's Premium Formula
The Ancient Secret Every Woman's Body Is Craving
Stop being the woman who gets sick every month. Your immune system wasn't meant to fail you - it was designed to be your fierce protector. PureFirst Milk Colostrum gives you back the bulletproof immunity you were born with.
What Every Woman Needs to Know?
You're not "just prone to getting sick." Your gut isn't "naturally sensitive." Your energy wasn't meant to crash at 3pm every day. You're missing nature's most powerful immune programming - the same liquid gold that keeps baby calves thriving in harsh conditions.
Why Your Body is Crying Out for This?
🔥 End the Sick Cycle
- No more being the mom/wife/friend who cancels plans because she's always sick
- Stop losing precious days to every bug that goes around
- Finally have the energy to show up as your best self
💫 Reclaim Your Glow
- Watch your skin transform from dull and tired to radiant and youthful
- Feel the confidence that comes with looking as good as you feel
- Get compliments on how "different" you look
⚡ Energy That Actually Lasts
- Wake up refreshed instead of dragging yourself out of bed
- Power through your day without that afternoon crash
- Feel vibrant enough for evening plans after a full day
🌸 Fix Your Gut, Fix Your Life
- End the bloating that makes you hide your body
- Stop the embarrassing digestive issues that control your social life
- Feel comfortable and confident in your own skin again
The Female-Focused Formula
2300mg of Pure Bovine Colostrum + 575mg Active Immunoglobulins - Specifically designed for women's unique immune and digestive needs!
Perfect for Women Who Are?
- Exhausted - from constantly fighting off illness
- Frustrated - with their unpredictable digestive system
- Fed up - with looking tired no matter how much sleep they get
- Ready - to feel like themselves again
- Determined - to age gracefully with vibrant health
The Transformation Timeline⏳
Week 1: Your gut starts healing - less bloating, better digestion
Week 2: Energy returns - you feel like YOU again
Week 3: Immunity kicks in - you don't catch what everyone else has
Month 2: Friends ask - what you're doing differently
Month 3: You realize - you haven't been sick in months
VonGIFTY™ - Care Commitment?
This isn't just another supplement that sits in your cabinet. This is nature's original superfood that transforms how you feel in your body every single day.
Stop settling for feeling "okay." Start living as the radiant, energetic woman you were designed to be.
-Easy Daily Ritual-
Mix into your morning smoothie, coffee, or water. That's it? One simple step to reclaim the vibrant, healthy woman you're meant to be.
Immune-Boosting Berry Colostrum
🍓Smoothie🍇
The Ultimate Women's Wellness Smoothie
This creamy, antioxidant-packed smoothie combines the immune-boosting power of colostrum with nutrient-dense berries for a delicious morning ritual that supports your health from the inside out.
Ingredients:
- 1 scoop ( or as directed ) PureFirstMilk Colostrum powder
- 1/2 cup frozen strawberries
- 1/4 cup fresh or frozen raspberries
- 1/4 cup fresh or frozen blueberries
- 1/2 ripe banana (for natural sweetness and creaminess)
- 3/4 cup unsweetened almond milk (or milk of choice)
- 1 tablespoon honey or maple syrup (optional, for extra sweetness)
- 1/2 cup ice cubes (if using fresh fruit)
- 1 teaspoon vanilla extract (optional)
Instructions:
- Add liquid first: Pour almond milk into your blender to help everything blend smoothly.
- Add colostrum powder: Mix in your PureFirstMilk Colostrum powder first to ensure it dissolves completely.
- Layer in fruit: Add banana, strawberries, raspberries, and blueberries.
- Enhance flavor: Add vanilla extract and sweetener if desired.
- Add ice: Include ice cubes for a thicker, more refreshing consistency.
- Blend: Start on low speed and gradually increase to high. Blend for 45-60 seconds until completely smooth and creamy.
- Adjust consistency: Add more liquid if too thick, or more ice/frozen fruit if too thin.
Pro Tips:
- For extra creaminess: Add 1/4 avocado ( you won't taste it! )
- Boost antioxidants: Include a handful of spinach for extra nutrients
- Make it tropical: Substitute mango or pineapple for some berries
- Protein boost: Add a scoop of vanilla protein powder
- Healthy fats: Include 1 tablespoon almond butter or chia seeds
Nutritional Benefits:
- Colostrum: Immune support, gut health, natural growth factors
- Mixed berries: High in antioxidants, vitamin C, and fiber
- Banana: Potassium, natural sweetness, and creamy texture
- Almond milk: Lower in calories, often fortified with vitamins
Perfect Timing:
- Morning: Start your day with immune support
- Pre-workout: Natural energy and recovery support
- Post-workout: Protein and nutrients for recovery
- Afternoon: Healthy snack to avoid energy crashes
Storage:
Best consumed immediately, but can be stored in the refrigerator for up to 24 hours. Shake or stir before drinking as separation is natural.
Serves 1 large smoothie ( approximately 16-20 oz )
Immune Green Goddess Colostrum
🥑Smoothie🥝
The Ultimate Women's Detox & Immunity Power Blend
This vibrant green smoothie combines nutrient-dense leafy greens with tropical fruits and immune-boosting colostrum for a smoothie that cleanses, energizes, and supports your body's natural defenses.
Ingredients:
- 1 scoop ( or as directed ) PureFirstMilk Colostrum powder
- 2 cups fresh baby spinach (packed)
- 1 ripe kiwi (peeled and chopped)
- 1/2 ripe banana (for natural sweetness)
- 1/4 cup fresh or frozen blueberries
- 3/4 cup coconut water (or water/almond milk)
- 1 tablespoon fresh lime juice (optional, for brightness)
- 1 teaspoon honey or agave (optional)
- 1/2 cup ice cubes
- Fresh mint leaves (for garnish and extra freshness)
Instructions:
- Start with liquid: Pour coconut water into blender for smooth blending.
- Add colostrum: Mix in PureFirstMilk Colostrum powder first.
- Layer greens: Add spinach leaves - don't worry, you won't taste them!
- Add fruits: Include banana, kiwi, and blueberries for natural sweetness and nutrients.
- Brighten it up: Add lime juice for extra vitamin C and fresh flavor.
- Sweeten if needed: Add honey or agave to taste.
- Add ice: For perfect consistency and refreshing temperature.
- Blend thoroughly: Start low and increase to high speed. Blend 60-90 seconds until completely smooth.
- Garnish: Add fresh mint leaves for an extra pop of freshness.
Why This Green Blend is Amazing?
- Spinach: Iron, folate, and vitamins A, C, K without any bitter taste
- Kiwi: More vitamin C than oranges, digestive enzymes, fiber
- Blueberries: Antioxidants for brain health and anti-inflammatory benefits
- Colostrum: Immune support, gut health, and natural growth factors
- Coconut water: Natural electrolytes and hydration
- Mint: Digestive support and refreshing flavor
Customization Options:
- Extra greens: Add kale or cucumber for more nutrients
- Tropical twist: Include frozen mango or pineapple
- Protein boost: Add vanilla protein powder
- Healthy fats: Include 1/4 avocado for creaminess
- Fiber boost: Add 1 tablespoon chia seeds or ground flaxseed
- Citrus kick: Try lemon juice instead of lime
Perfect For:
- Morning detox: Start your day with cleansing nutrients
- Pre-workout: Natural energy and hydration
- Post-workout: Recovery with electrolytes and protein
- Afternoon reset: Healthy way to beat the midday slump
- Digestive support: Gentle on the stomach with immune benefits
Health Benefits:
- Natural detoxification from chlorophyll-rich greens
- Immune system support from colostrum and vitamin C
- Digestive wellness from fiber and natural enzymes
- Sustained energy without sugar crashes
- Hydration boost from coconut water and high water content fruits
Pro Tips:
- Freeze your spinach: Frozen spinach blends smoother and makes the smoothie colder
- Ripe kiwi is key: Make sure your kiwi is soft for the best sweetness
- Don't skip the mint: It adds amazing freshness and aids digestion
- Make it ahead: Prep ingredients in freezer bags for quick morning blending
Storage:
Best consumed immediately for maximum nutrient retention and fresh taste. Can be refrigerated for up to 24 hours - shake well before drinking.
Serves 1 large smoothie ( approximately 16-20 oz )
Immune Blue Goddess Colostrum
🍇Smoothie🥥
Antioxidant Powerhouse for Ultimate Brain & Immune Support
This stunning blue smoothie combines the cognitive benefits of blueberries and blackberries with immune-boosting colostrum for a smoothie that supports both mental clarity and physical wellness.
Ingredients:
- 1 scoop (or as directed) PureFirstMilk Colostrum powder
- 3/4 cup frozen blueberries
- 1/4 cup fresh or frozen blackberries
- 1/2 ripe banana (for natural sweetness and creaminess)
- 3/4 cup coconut milk (or milk of choice)
- 1 tablespoon almond butter (for healthy fats and protein)
- 1 teaspoon honey or maple syrup (optional)
- 1/2 cup ice cubes (if using fresh fruit)
- 1/2 teaspoon vanilla extract (optional)
Instructions:
- Liquid base: Pour coconut milk into blender first for smooth blending.
- Add colostrum: Mix in PureFirstMilk Colostrum powder to ensure complete dissolution.
- Add fruits: Include banana, blueberries, and blackberries for that beautiful blue color.
- Boost nutrition: Add almond butter for healthy fats and extra creaminess.
- Enhance flavor: Include vanilla and sweetener if desired.
- Add ice: For perfect thickness and refreshing temperature.
- Blend: Start low and increase to high speed. Blend 60-90 seconds until completely smooth.
- Serve immediately: Garnish with a fresh blueberry on the rim.
Why This Combination Works?
- Blueberries: Highest antioxidant content of all berries, supports brain health
- Blackberries: Rich in vitamins C and K, adds fiber and deep color
- Colostrum: Immune system support and gut health benefits
- Banana: Natural sweetness, potassium, and creamy texture
- Coconut milk: Healthy medium-chain fatty acids
- Almond butter: Protein, healthy fats, and sustained energy
Customization Options:
- Brain boost: Add 1 tsp MCT oil or 1 tbsp chia seeds
- Protein power: Include vanilla protein powder
- Extra antioxidants: Add a handful of spinach (won't affect taste)
- Tropical twist: Use frozen mango instead of banana
- Creamier texture: Add 1/4 avocado
Perfect For:
- Morning fuel: Start your day with brain-boosting antioxidants
- Pre-workout: Natural energy without the crash
- Post-workout: Recovery support with protein and nutrients
- Afternoon pick-me-up: Healthy alternative to coffee
Health Benefits:
- Cognitive support from blueberry anthocyanins
- Immune system boost from colostrum immunoglobulins
- Digestive wellness from colostrum and fiber-rich berries
- Anti-inflammatory compounds from dark berries
- Sustained energy from healthy fats and natural sugars
Storage:
Best consumed fresh, but can be refrigerated for up to 24 hours. The beautiful blue color may darken slightly over time due to natural oxidation.
Serves 1 large smoothie ( approximately 16-20 oz )
Elevate your wellness routine with this antioxidant-rich smoothie that tastes as amazing as it looks.
Your future self will thank you!

📦VonGIFTY™ Quality Shipping📦
Collapsible content

Shipping Times
- FREE SHIPPING: United States via USPS Estimated delivery: 4-7days
VonGIFTY™ Premium Shipping Promise: Delivering Confidence to Your Door
Our Commitment to Discrete, Premium Delivery 📦
At VonGIFTY™, we understand that receiving your intimate wellness products should be as confidential and premium as our products themselves. Every shipment is handled with the utmost care and discretion to ensure your privacy and satisfaction.
🌟 Premium Shipping Timeline
Standard Production Times:
- Ready-to-ship items: 2-3 business days
- Custom designs: 5-7 business days
- Premium collections: 2-4 business days
✨ Your Premium Shipping Options
Discrete Standard Shipping
- 5-7 business days
- Plain, unmarked packaging
- Tracking provided
- Most economical option
Expedited Delivery
- 2-3 business days
- Priority handling
- Enhanced tracking
- Signature confirmation available
Express Premium Service
- Next day delivery available
- Premium handling
- Real-time tracking
- Priority processing
💫 The VonGIFTY™ Shipping Experience
Our Premium Packaging Promise:
- Discreet, unmarked boxes
- Secure, protective materials
- Eco-conscious packaging
- No external branding
- Tamper-evident seals
Quality Control Measures:
- Pre-shipping inspection
- Secure sealing process
- Weather-protective packaging
- Address verification
- Insurance options available
📋 Shipping Details You Should Know
Processing Times:
- Orders confirmed: Same day
- Processing begins: Next business day
- Weekend orders: Processed Monday
- Holidays: May affect timeline
International Orders:
- Available to select countries
- Custom processing times
- Country-specific regulations
- Additional documentation provided
🌍 Delivery Considerations
We Monitor:
- Weather conditions
- Transportation networks
- Customs requirements
- Local regulations
- Service disruptions
Your Peace of Mind:
- Real-time tracking
- Delivery notifications
- Secure handling
- Insurance options
- Signature confirmation available
📱 Stay Connected
Track your VonGIFTY™ order:
- Email notifications
- SMS updates available
- Online tracking portal
- Customer service support
💎 Premium Customer Care
Questions about your shipment? Email: vongiftyinfo@gmail.com Response time: Within 24 hours
We're Here to Help With:
- Tracking updates
- Delivery questions
- Special instructions
- Address changes
- Shipping upgrades
⭐ The VonGIFTY™ Delivery Difference
We ensure:
- Privacy first approach
- Secure handling
- Quality protection
- Timely delivery
- Premium service
VonGIFTY™ - Delivering Confidence and Care
#VonGIFTYDelivery #PremiumShipping #DiscreteDelivery #QualityAssured
© VonGIFTY™ - Premium Care from Click to Delivery
For special shipping requirements or questions, our dedicated shipping team is here to help.
Note: Delivery times may vary during peak seasons, holidays, or due to circumstances beyond our control. We'll keep you informed every step of the way.